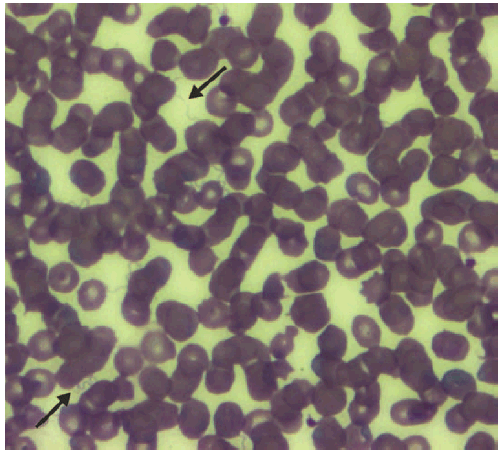
The figure shows a stained thin smear of peripheral blood from a newborn child (born in Colorado in 2011) and indicates the presence of numerous spirochetes, consistent with infection with tickborne relapsing fever.

Persons using assistive technology might not be able to fully access information in this file. For assistance, please send e-mail to: mmwrq@cdc.gov. Type 508 Accommodation and the title of the report in the subject line of e-mail.
Tickborne Relapsing Fever in a Mother and Newborn Child — Colorado, 2011
Tickborne relapsing fever (TBRF) is a bacterial infection caused by certain species of Borrelia spirochetes and transmitted through the bite of Ornithodoros ticks. Clinical illness is characterized by relapsing fever, myalgias, and malaise. On May 10, 2011, CDC and the Colorado Department of Public Health and Environment were notified of two patients with TBRF: a young woman and her newborn child. This report summarizes the clinical course of these patients and emphasizes the importance of considering a diagnosis of TBRF among patients with compatible clinical symptoms and residence or travel in a TBRF-endemic area. Pregnant women and neonates are at increased risk for TBRF-associated complications and require prompt diagnosis and treatment for optimal clinical outcomes. Public health follow-up of reported TBRF cases should include a search for persons sharing an exposure with the patient and environmental investigation with remediation measures to prevent additional infections.
On May 2, 2011, a previously healthy woman aged 24 years sought treatment at a local emergency department in Colorado after 1 week of fever, nausea, headache, stiff neck, and occasional blurred vision. Approximately 20 hours earlier, she had delivered a newborn (at 39 weeks' gestation) in a mountain cabin, without medical attendance. She had received limited prenatal care. Delivery was notable for amniotic fluid discoloration consistent with meconium. Physical examination revealed an ill-appearing and afebrile woman with hypotension (blood pressure: 70/40 mmHg). Gynecologic examination was unremarkable. A complete blood count revealed an elevated white blood cell count of 18,000/µL (normal: 4,500–10,000/µL), a decreased hematocrit of 30% (normal: 37%–47%), and a decreased platelet count of 42,000/µL (normal: 130,000–400,000/µL). Blood chemistries were remarkable for an elevated creatinine of 1.6 mg/dL (normal: 0.6–1.3 mg/dL), elevated aspartate aminotransferase of 61 IU/L (normal: 15–37 IU/L), and elevated alkaline phosphatase of 422 IU/L (normal: 50–136 IU/L). She was admitted and treated empirically using intravenous piperacillin with tazobactam for postpartum sepsis and fluid resuscitation for hypotension. Antibiotics were changed to oral amoxicillin after 48 hours. A blood culture drawn at admission revealed no growth, and the patient remained afebrile during hospitalization. Because of worsening anemia, she was transfused with packed red blood cells on May 3. Her condition improved, and she was discharged on May 5.
The newborn female accompanied her mother to the emergency department on May 2. Although physical examination was normal, the newborn was admitted for observation. An initial complete blood count was unremarkable, and blood culture collected at admission had no growth after 5 days. The patient developed neonatal jaundice on May 4 and remained hospitalized. On May 7, she became febrile with a temperature of 101.2°F (38.4°C) and had a platelet count of 34,000/µL (normal: 130,000–400,000/µL). Blood chemistries revealed an elevated alkaline phosphatase of 196 IU/L (normal: 50–136 IU/L) and a decreased albumin of 2.4 g/dL (normal: 3.4–5.0 g/dL). Treatment for sepsis was initiated with administration of gentamicin, ampicillin, and acyclovir. Subsequently, her platelet count decreased further to 14,000/µL. A review of the peripheral blood smear to evaluate the newborn's thrombocytopenia incidentally revealed spirochetes consistent with TBRF (Figure). A 10-day course of intravenous penicillin-G and platelet transfusions for progressive thrombocytopenia were initiated. The newborn recovered and was discharged on May 20. Because of the newborn's spirochetemia, the mother was presumptively treated for TBRF with doxycycline.
Blood and serum samples from the mother and her newborn were tested by CDC's Bacterial Diseases Branch, Fort Collins, Colorado. Presence of spirochetes was visually confirmed from the newborn's blood smear prepared May 7; a whole blood sample collected the same day yielded evidence of relapsing fever Borrelia species by polymerase chain reaction. Sequencing of polymerase chain reaction targets revealed 100% match to Borrelia hermsii. Testing of the newborn's serum also obtained May 7 did not detect B. hermsii antibodies by either enzyme immunoassay (EIA) or immunoglobulin M (IgM) and immunoglobulin G (IgG) Western immunoblots. A sample collected from the newborn 3 days later had equivocal results by EIA and three bands visible on IgM immunoblot and one band visible on IgG immunoblot. Serum collected from the mother on May 13 produced a positive B. hermsii EIA, >10 bands by IgM immunoblot, and 10 bands by IgG immunoblot. The mother's clinical history and dominant IgM antibody response supported acute maternal B. hermsii infection acquired during the weeks preceding delivery; the limited antibody response by the newborn also supported a diagnosis of acute TBRF infection.
The mother was not employed and had moved from a densely populated urban area in Colorado to the previously vacant cabin 18 days before delivery. This rural Colorado cabin was situated near the base of a mountain range within a juniper and piñon tree forest at an approximate elevation of 8,800 feet. The single-room structure lacked electricity and running water. An environmental assessment indicated no ongoing rodent activity, and no ticks were recovered. The cabin owner declined to permit access to internal wall spaces to search for rodent nests.
Reported by
Elisabeth W. Lawaczeck, DVM, Colorado Dept of Public Health and Environment. Paul S. Mead, MD, Martin E. Schriefer, PhD, Div of Vector-Borne Diseases, National Center for Emerging and Zoonotic Infectious Diseases; Meghan E. Brett, MD, Jeffrey T. McCollum, DVM, EIS officers, CDC. Corresponding contributor: Jeffrey T. McCollum, jmccollum@cdc.gov, 303-692-2745.
Editorial Note
B. hermsii is the most frequent cause of TBRF in the United States. This spirochete is transmitted to humans by the soft tick Ornithodoros hermsi, which usually is associated with the nests of chipmunks and other wild rodents (1). Unlike hard ticks, O. hermsi transmit spirochetes through a brief (<30 minutes' duration) and painless nocturnal bite. Humans typically are exposed to these ticks during an overnight stay in rodent-infested dwellings at elevations >2,000 feet.
After an average incubation period of 7 days (range: 2–18 days), TBRF symptoms include fever, headache, myalgias, nausea, and chills with a median duration of 3 days (range: 2–7 days) alternating with afebrile periods of a median duration of 7 days (range: 4–14 days) (1). Febrile periods can recur ≤10 times without treatment. Moderate to severe thrombocytopenia is typical during acute TBRF illness (1). As occurred in the newborn's illness, spirochetes are not detected by automated blood cell counts but can be observed on direct examination of stained (Wright's or Giemsa) blood smears, with sensitivity approaching 70% during febrile episodes (2). Blood smears most often reveal spirochetes during acute infection and before antibiotic treatment. Alternatively, serologic testing for TBRF can be used for diagnosis but is not widely available. Antibiotics recommended for treatment include penicillin, doxycycline, and erythromycin. Patients with TBRF infection should be monitored for ≥2 hours after initial antibiotic dose for a Jarisch-Herxheimer reaction, an acute worsening of symptoms that can be life-threatening.* One case series documented such reactions among 54% of patients, demonstrating that this reaction is common (3).
TBRF infection can pose serious risks for mothers and neonates. Only 12 TBRF infections among pregnant women have ever been reported in the United States, including the one in this report (1,3–9). Among these cases, serious maternal complications of TBRF infection have been documented and include adult respiratory distress syndrome, Jarisch-Herxheimer reaction, and precipitous or premature delivery (4–6). Among newborns born to these TBRF-infected mothers, six (55%) of 11 had a documented perinatal TBRF infection; two (33%) died despite treatment.† Potential routes of perinatal TBRF infection include transplacental transmission or acquisition during delivery; however, studies have been limited.
The findings in this report are subject to at least two limitations. First, transmission route for the newborn was not determined, but possibilities include transplacental, during birth, or during residence in the cabin. Second, the cabin remains the most likely site of exposure for the mother on the basis of arrival date and acute nature of her illness; however, no rodent nests or ticks were identified within the structure to provide more substantial evidence.
TBRF should be considered a potential diagnosis among febrile patients who reside in or have traveled to the western United States, especially those inhabiting rustic housing. Cases should be reported immediately to public health officials to facilitate identification of other potentially exposed persons and to evaluate and treat those persons for TBRF infection. Additionally, TBRF is a reportable disease in 12 western U.S. states.§ An environmental investigation should be undertaken to search for rodent nests. Reinfection and additional TBRF illnesses can occur in housing previously linked to TBRF cases (10). Remediation efforts should include rodent-proofing and treatment of structures with pesticides (particularly crack- and crevice-type) by pest control specialists to reduce risk for continued tick exposure.
Acknowledgments
Local clinicians and clinical laboratories; local health department personnel; Ken Gershman, MD, Communicable Disease Epidemiology Program, Colorado Dept of Public Health and Environment. Christopher Sexton, John Young, Bacterial Diseases Branch Laboratory, Div of Vector-Borne Diseases; Kris Bisgard, DVM, EIS Field Assignments Branch, Scientific Education and Professional Development Program Office, CDC.
References
- Dworkin MS, Schwan TG, Anderson DE Jr. Tick-borne relapsing fever in North America. Med Clin North Am 2002;86:417–33, viii–ix.
- Southern PM Jr, Sanford JP. Relapsing fever: a clinical and microbiological review. Medicine 1969;48:129–49.
- Dworkin MS, Anderson DE Jr, Schwan TG, et al. Tick-borne relapsing fever in the northwestern United States and southwestern Canada. Clin Infect Dis 1998;26:122–31.
- Davis RD, Burke JP, Wright LJ. Relapsing fever associated with ARDS in a parturient woman. A case report and review of the literature. Chest 1992;102:630–2.
- Guggenheim JN, Haverkamp AD. Tick-borne relapsing fever during pregnancy: a case report. J Reprod Med 2005;50:727–9.
- Fuchs PC, Oyama AA. Neonatal relapsing fever due to transplacental transmission of Borrelia. JAMA 1969;208:690–2.
- Morrison SK, Parsons L. Relapsing fever: report of three cases, one in a six day old infant. JAMA 1941;116:220–1.
- Steenbarger JR. Congenital tick-borne relapsing fever: report of a case with first documentation of transplacental transmission. Birth Defects Orig Artic Ser 1982;18(3 Pt A):39–45.
- Malison MD. Relapsing fever. JAMA 1979;241:2819–20.
- Wynns HL. The epidemiology of relapsing fever. In: In: Moulton FR, ed. A symposium on relapsing fever in the Americas. Washington, DC: American Association for the Advancement of Science; 1942.
* A Jarisch-Herxheimer reaction is characterized by hypotension, tachycardia, chills, rigors, diaphoresis, and elevated body temperature and can occur after initial antibiotic therapy for infections caused by spirochetes, including relapsing fever (1).
† One woman with TBRF infection elected to terminate her pregnancy.
§ Arizona, California, Colorado, Idaho, Montana, Nevada, New Mexico, North Dakota, Oregon, Texas, Utah, and Washington.
What is already known on this topic?
Tickborne relapsing fever (TBRF) is a spirochetal infection transmitted to humans through the bites of soft ticks. TBRF infection is endemic to the western United States and often acquired by patients lodging in rodent-infested rustic dwellings at elevations >2,000 feet.
What is added by this report?
This report describes the sixth reported case of acute neonatal TBRF infection associated with maternal TBRF illness in the United States. It highlights the incidental diagnosis of two TBRF infections, indicating that TBRF might not be considered initially for clinically compatible illnesses even in TBRF-endemic areas.
What are the implications for public health practice?
TBRF should be considered among the differential diagnoses of patients with unexplained or recurrent fever, especially those with a history of travel or residence in areas where TBRF is endemic. Pregnant women and neonates are at increased risk for severe TBRF illness and require prompt diagnosis and treatment for optimal clinical outcomes. Public health follow-up of reported TBRF cases should include a search for additional illnesses and environmental assessment with remediation measures to prevent further infections or reinfection.
FIGURE. Stained thin smear of a newborn's peripheral blood, showing the presence of numerous spirochetes (indicated by black arrows) at 63X magnification — Colorado, 2011
Photo/CDC
Alternate Text: The figure above shows a stained thin smear of peripheral blood from a newborn child (born in Colorado in 2011) and indicates the presence of numerous spirochetes, consistent with infection with tickborne relapsing fever.
Use of trade names and commercial sources is for identification only and does not imply endorsement by the U.S. Department of
Health and Human Services.
References to non-CDC sites on the Internet are
provided as a service to MMWR readers and do not constitute or imply
endorsement of these organizations or their programs by CDC or the U.S.
Department of Health and Human Services. CDC is not responsible for the content
of pages found at these sites. URL addresses listed in MMWR were current as of
the date of publication.
All MMWR HTML versions of articles are electronic conversions from typeset documents.
This conversion might result in character translation or format errors in the HTML version.
Users are referred to the electronic PDF version (http://www.cdc.gov/mmwr)
and/or the original MMWR paper copy for printable versions of official text, figures, and tables.
An original paper copy of this issue can be obtained from the Superintendent of Documents, U.S.
Government Printing Office (GPO), Washington, DC 20402-9371;
telephone: (202) 512-1800. Contact GPO for current prices.
**Questions or messages regarding errors in formatting should be addressed to
mmwrq@cdc.gov.


